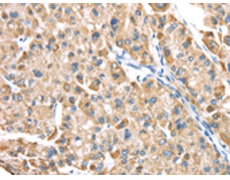
一抗

|
Background: |
Low-affinity receptor for leukotrienes including leukotriene B4. Mediates chemotaxis of granulocytes and macrophages. The response is mediated via G-proteins that activate a phosphatidylinositol-calcium second messenger system. The rank order of affinities for the leukotrienes is LTB4 > 12-epi-LTB4 > LTB5 > LTB3. |
|
Applications: |
ELISA, IHC |
|
Name of antibody: |
LTB4R2 |
|
Immunogen: |
Synthetic peptide of human LTB4R2 |
|
Full name: |
leukotriene B4 receptor 2 |
|
Synonyms: |
BLT2; NOP9; BLTR2; JULF2; KPG_004; LTB4-R2; LTB4-R 2 |
|
SwissProt: |
Q9NPC1 |
|
ELISA Recommended dilution: |
2000-5000 |
|
IHC positive control: |
Human liver cancer and Human esophagus cancer |
|
IHC Recommend dilution: |
20-100 |

 購物車
購物車 幫助
幫助
 021-54845833/15800441009
021-54845833/15800441009